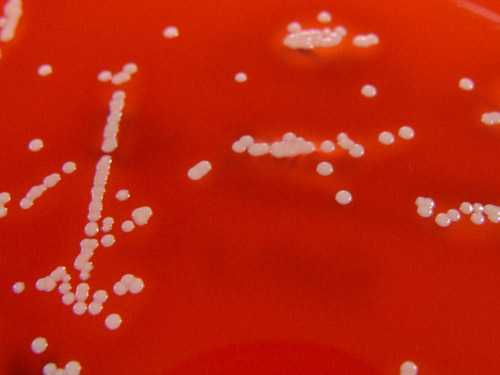

Staphylococcus haemolyticus, гемолитический стафилококк — свойства, норма в мазке, лечение
Гемолитический стафилококк — условно-патогенный микроорганизм, обитающий в организме здорового человека и способный при определенных условиях вызывать инфекционно-воспалительные и гнойно-деструктивные процессы. Он разрушает клетки крови — эритроциты и поражает кожный покров, слизистую оболочку респираторного, урогенитального и пищеварительного трактов. Благодаря способности к гемолизу микроб и получил свое название.
Staphylococcus haemolyticus устойчив к большинству антибактериальных и антисептических средств. По результатам антибиотикограммы специалисты выбирают лекарственный препарат. Гемолитический стафилококк проявляется и лечится достаточно необычно, поскольку его действие связано с проникновением в кровь и уничтожением ее элементов.
Приобретая патогенные свойства, бактерия поражает преимущественно верхние дыхательные пути у детей и взрослых. Она вызывает гнойный тонзиллит или фарингит. Сначала инфекция протекает по типу ОРВИ, затем насморк и кашель сменяются болью и покраснением горла. Патологическое воздействие наблюдается у лиц с ослабленным иммунитетом.Этиология и эпидемиология
Staphylococcus haemolyticus на кровяном агаре
Гемолитический стафилококк — грамположительный неподвижный кокк, располагающийся в мазке хаотично или скоплениями. Он является факультативным анаэробом: может существовать без доступа воздуха. Спор не образует и растет на питательных средах, содержащих кровь. Обычно в микробиологических лабораториях используют кровяной агар для определения основного свойства микроба — способности вызывать гемолиз эритроцитов. Бактерии устойчивы к замораживанию, нагреванию, солнечным лучам и некоторых химикатам. Оптимальная температура для жизнедеятельности стафилококка – 30-37°C. Микроб быстро приспосабливается к воздействию антибиотиков и антисептиков.
Staphylococcus haemolyticus в качестве факторов патогенности использует эндотоксин, ферменты и гемолизины, благодаря которым происходит развитие гнойной ангины, фарингита, бронхита, пневмонии и прочих воспалительных заболеваний внутренних органов. Под воздействием стафилококкового токсина нарушается обмен веществ на клеточном уровне, ухудшается общее состояние больных, появляются неврологические симптомы.
Гемолитический стафилококк широко распространен в природе. Большинство жителей нашей планеты являются бактерионосителями. Он считается нормальным обитателем организма человека и не представляет никакой опасности для лиц, имеющих крепкий иммунитет. Лица с активно функционирующей иммунной системой надежно защищены. Процесс размножения стафилококка и приобретения патогенных свойств подавляется нормальной микрофлорой макроорганизма. При снижении общей резистентности и ослаблении защитных сил микроб вызывает различные заболевания. Патогенные штаммы могут проникать в организм извне в результате контакта с бактерионосителем.
Факторы, повышающие патологическую активность микроба:
- Антисанитарные условия,
- Перенаселенность,
- Нездоровая пища,
- Хронический стресс,
- Гиподинамия,
- Гиповитаминоз,
- Имеющиеся хронические заболевания,
- Нарушение гигиенических норм и правил,
- Дисбактериоз,
- Слабый иммунитет,
- Бесконтрольное употребление антибактериальных препаратов.
Staphylococcus haemolyticus вызывает гнойные воспалительные заболевания органов дыхания, которые с трудом поддаются терапии. Он обнаруживается в ходе бактериологического исследования отделяемого зева у больных ангиной в 70% случаях. При хроническом тонзиллите гемолитический стафилококк высевается примерно у 50% обследованных. Бактерии являются сверхустойчивыми. Они сохраняются на миндалинах и в носоглотке в неактивном состоянии даже после курса противомикробной терапии и передаются восприимчивым людям.
Механизмы и пути распространения гемолитического стафилококка:
- Аэрозольный механизм, реализующийся воздушно-капельным путем — в результате общения с больным человеком, особенно, когда он часто кашляет и чихает;
- Контактный механизм, реализующийся контактно-бытовым путем — через грязные руки, инфицированные предметы быта и обихода;
- Фекально-оральный механизм, реализующийся алиментарным путем — при употреблении некачественных продуктов питания;
- Гемоконтактный путь — при использовании нестерильного медицинского инструментария,
- Вертикальный путь — во время родов от матери к ребенку.
- Дети,
- Пожилые люди,
- Беременные женщины,
- Лица с ослабленным иммунитетом,
- Низшие слои населения.
Микробы проникают в организм человека и колонизируют эпителий респираторного тракта, но не проявляют своей патогенной активности благодаря полноценной работе иммунной системы. Гемолитический стафилококк в таком состоянии не причиняет вреда здоровью и не определяется в лабораторных анализах. Иногда обнаруживается минимальное количество бактерий, безопасное для человека. Когда иммунная защита ослабевает, микроб активизируется, быстро размножается и распространяется по всему организму. При попадании бактерий в кровь они проявляют свое основное патогенное действие – разрушают эритроциты.
Симптоматика
Гемолитический стафилококк является возбудителем различных заболеваний органов дыхания – ангины, фарингита, пневмонии; урогенитального тракта — у мужчин уретрита и простатита, у женщин цистита или цервицита; кожного покрова — импетиго, рожи; септических процессов — эндокардита, абсцессов, сепсиса.

Инкубационный период при данной инфекции длится в среднем двое суток. Сначала у больных ухудшается общее состояние, а затем появляются катаральные симптомы.
- К общим симптомам интоксикации и астенизации при стафилококковой инфекции относятся: слабость, недомогание, лихорадка, тошнота, метеоризм, ломота во всем теле, озноб, плохое самочувствие, вялость, разбитость, снижение аппетита, цефалгия, нарушение сна.
- При поражении органов дыхания появляются характерные симптомы: из носа выделяется слизисто-гнойный секрет, в горле першит, слизистая краснеет, миндалины отекают и покрываются гнойным налетом, возникает боль, кашель с гнойной мокротой, чихание. У детей тонзиллит, вызванный гемолитическим стрептококком, часто осложняется отитом, лимфаденитом, скарлатиной.
- Воспаление органов мочеполовой системы у мужчин, вызванное гемолитическим стафилококком, проявляется частым мочеиспусканием с режущей болью и зудом, появлением крови в моче и других патологических примесей, дискомфортом в промежности, гнойным отделяемым из уретры, эректильной дисфункцией. У мужчин микроб часто вызывает воспаление предстательной железы. Он проникает в секрет простаты гематогенным путем из инфицированных внутренних органов, контактным путем в результате половых актов, в процессе инвазивных медицинских манипуляций, при несоблюдении правил личной гигиены.
- Симптомы поражения половых органов гемолитическим стафилококком у женщин: выделения с неприятным запахом, зуд, ощущение сухости во влагалище, боль во время полового акта, жжение в половых путях, усиливающееся в ночное время, повышенная раздражительность слизистой.
- На коже больных появляются гнойнички или фурункулы, в мягких тканях образуются абсцессы.
Диагностика
Диагностика заболеваний, вызванных гемолитическим стафилококком, заключается в проведении микробиологического исследования биоматериала, полученного от больного. В лабораторию его доставляют в течение 2 часов от момента отбора, сразу засевают на питательные среды и инкубируют в термостате. После микроскопии выросших колоний и накоплении чистой культуры проводят окончательную идентификацию выделенного микроба.

Бактериологическое исследование биоматериала проводится с целью выделения возбудителя патологии и определения его чувствительности к антибиотикам. Материалом для исследования является отделяемое носоглотки, моча, мазок из гнойных образований кожи, грудное молоко, влагалищный секрет, кал, отделяемое уретры, секрет простаты. Посев производят на кровяной агар, приготовленный из обычного питательного агара с добавлением дефибринированной крови барана, лошади или КРС. Чашки инкубируют в термостате в течение 24 часов, а затем описывают характер выросших колоний. Они имеют белый или кремовый цвет и выраженную зону гемолиза по периферии. Проводят микроскопию окрашенных по Грамму мазков. Изучают морфологические и тинкториальные свойства, ставят дополнительные тесты. С целью определения массивности обсеменения проводят количественный анализ. Подсчитывают число характерных колоний на чашке Петри и определяют значение колониеобразующих единиц.
В норме у здорового человека количество Staphylococcus haemolyticus должно быть не более 103 степени КОЕ. Если показатели превышают 106 степени, это говорит о высокой интенсивности инфицирования.
Дополнительно всем больным назначают сдать кровь и мочу на общеклинический анализ с целью выявления признаков воспаления и поражения органов. В общем анализе крови обнаруживают лейкоцитоз, нейтрофилез, подъем СОЭ, в анализе мочи — протеинурию, лейкоцитурию, бактериурию. Фаготипирование стафилококка — определение его чувствительности к фагам-вирусам для назначения соответствующего лечения. ПЦР-диагностика позволяет определить возбудителя заболевания по ДНК.
Лечение
Лечение гемолитического стафилококка сложное, длительное, этиотропное, противомикробное. Больным показан прием антибиотиков, иммуномодуляторов, десенсибилизирующих средств. Хороший эффект дает физиотерапия и местное применение антисептиков, бактериофагов.
Лечением больных занимаются специалисты разного профиля – дерматологи, ЛОРы, терапевты, гинекологи, урологи, педиатры и инфекционисты.
Антибактериальные препараты назначают после проведения специального теста на чувствительность выделенного микроорганизма к противомикробным средствам. Гемолитический стафилококк имеет повышенную устойчивость к некоторым антибиотикам. Чаще всего используют пенициллины «Амоксициллин», «Аугментин», цефалоспорины «Цефалотин», «Цефтриаксон», макролиды «Азитромицин», «Кларитромицин», а также «Ванкомицин», «Оксациллин». Лечение антибиотиками начинают, когда количество колониеобразующих единиц стафилококка превышает 10 в 4 степени. Антибиотикотерапия длится обычно 10-14 дней.- Если лечение антибиотиками не дает положительных результатов, применяют стафилококковый бактериофаг или анатоксин. Особенно эффективны эти средства для лечения воспаления в ЖКТ и мочеполовой системе. Бактериофаг поселяется в организме и начинает питаться стафилококком. При поражении верхних дыхательных путей в носовые проходы вводят марлевые турунды, пропитанные бактериофагом, а при поражении кишечника используют клизмы с этим средством. Жидкий раствор бактериофага в чистом виде вводят в мочевыводящие пути через специальный катетер при уретрите или цистите. У мужчин инфекция наружных половых органов лечится примочками. Гнойную ангину лечат путем орошения полости рта бактериофагом. При отите раствор закапывают в ушную раковину больного. Для лечения фурункулеза назначают пероральный прием препарата в комплексе с инъекциями бактериофага.
- Иммуномодулирующая терапия широко применяется в комплексном лечении гемолитического стафилококка. Больным назначают «Ликопид», «Имунорикс», «Исмиген».
- Антигистаминные препараты снимают отек и устраняют зуд – «Супрастин», «Тавегил», «Зиртек».
- Для нормализации температуры тела применяют жаропонижающие средства – «Ибуклин», «Нурофен», для снятия головной боли – «Пенталгин», «Анальгин». Симптоматическую терапию часто дополняют спазмолитиками, бронхолитиками, муколитиками.
- В тяжелых случаях показаны методы дезинтоксикации — внутривенное введение солевых и коллоидных растворов, пероральное применение «Регидрона».
- Местное лечение заключается в обработке носа антисептиками «Фурацилином», «Хлоргексидином», «Хлорофиллиптом», орошении зева противомикробными спреями, рассасывании пастилок и леденцов «Стрепсилс», «Септолете», «Доктор Мом».
- Курсовой прием минерально-витаминных комплексов улучшает общее состояние пациентов и помогает быстрее восстановиться после болезни.
- Физиотерапевтические процедуры назначают после снятия острых признаков воспаления. Наиболее эффективными являются: УФО, УВЧ, ультразвук, магнитотерапия, лазерное облучение, аппаратное промывание миндалин.
- Средства народной медицины: спиртовые и масляные растворы хлорофиллипта для полоскания воспаленного горла; употребление ягод черной смородины для укрепления иммунитета; настой листьев лопуха для приема внутрь; прикладывание мякоти абрикос к пораженной стафилококком коже; прием ванн с добавлением яблочного уксуса; настойка прополиса для полоскания горла; экстракты алоэ и эхинацеи – мощные природные антибиотики и сильные иммуностимуляторы.
Осложнения заболеваний, вызванных гемолитическим стафилококком, развиваются при отсутствии своевременной и полноценной терапии. К ним относятся сепсис, ревматизм, патология сердца и почек.
Профилактика
Профилактические мероприятия, предупреждающие заражение гемолитическим стафилококком и блокирующие его размножения в организме:
- Соблюдение правил личной гигиены,
- Санация очагов хронической инфекции — лечение кариеса, тонзиллита, отита, гайморита,
- Укрепление иммунитета — закаливание, пешие прогулки на свежем воздухе, правильное питание, физическая культура, полноценный сон,
- Профилактический прием витаминов и микроэлементов,
- Регулярная влажная уборка помещения и частое проветривание,
- Применение антибиотиков только по назначению врача,
- Профилактика стрессов и эмоционального перенапряжения,
- Соблюдение санитарных норм и гигиенических правил в ЛПУ,
- Своевременное выявление и изоляция больных,
- Правильный уход за новорожденными.
Гемолитический стафилококк — бактерия, обитающая в различных локусах организма здорового человека. Микробы в обычных условиях не причиняют вреда и не являются опасными. Под воздействием негативных экзогенных или эндогенных факторов иммунная система перестает нормально функционировать и полноценно защищать организм. Staphylococcus haemolyticus активизируется и вызывает развитие патологического процесса.
Видео: когда не нужно лечить стафилококк? – Доктор Комаровский
Видео: стафилококк в программе “Жить здорово!”
Мнения, советы и обсуждение:
uhonos.ru
симптомы, мазок и посев при диагностике
Стафилококки представляют собой большую группу вредоносных бактерий, вызывающих у человека различные болезни инфекционного характера, что в дальнейшем грозит серьёзными и трудно поддающимися лечению осложнениями. К этому виду патогенных микроорганизмов относится и гемолитический стафилококк (Staphylococcus haemolyticus). Вредоносные бактерии локализуются в организме мужчины в виде скоплений, по своей структуре напоминающих гроздь винограда.
Основной особенностью этого вида стафилококков является их способность проникать в кровь человека, вызывая тем самым разрушение эритроцитов.
Заражение гемолитическим стафилококком, симптомы
Инфицирование человека происходит только посредством контакта с вредоносной бактерией. Наиболее распространёнными путями заражения считаются следующие:
- контактно-бытовой;
- пищевой;
- воздушно-капельный.
Бактерии гемолитического стафилококка попадают в окружающую среду при кашле или даже просто разговоре больного человека. Попавшие в воздух микроорганизмы оседают на личных вещах, продуктах питания, предметах обихода.
Причины заболевания
Больше всего шансов заразиться гемолитическим стафилококком имеют люди, не соблюдающие элементарных правил личной гигиены.
Стафилококковые бактерии могут спровоцировать вторичное заражение тканей. Так, при малейшем повреждении кожного покрова (ранки, ссадины и пр.) патогенные микроорганизмы провоцируют развитие гнойного воспаления в тканях. Стафилококковая бактерия занимает место погибшей микрофлоры в поражённом органе либо тканях.
Поскольку стафилококк способен вызвать некроз, на поражённом участке происходит отмирание клеток, и возникает нагноение. Бактерии вырабатывают экзотоксин, благодаря чему происходит сильная интоксикация поражённых тканей.
Также развитию инфекции способствуют следующие факторы:
- дисбактериоз;
- вирусные заражения;
- заболевания инфекционного характера;
- чрезмерное употребление антибактериальных препаратов;
- разного рода хронические патологии.
Людям с крепкой иммунной защитой не стоит переживать по поводу инфекции стафилококка. Однако, как только иммунитет ослабевает, болезнетворные микроорганизмы начинают активное размножение, что может привести к различным патологиям внутренних органов и систем организма.
Бактерии гемолитического стафилококка могут спровоцировать развитие таких недугов, как:
- Цистит и поражение уретры, что выражается в появлении болевого синдрома, гнойных выделениях и учащённом мочеиспускании.
- Поражения кожного покрова, которые сопровождаются гнойными воспалительными процессами (появление гнойничков, фурункулов, развитие абсцессов).
- Поражения верхних дыхательных путей, сопровождаемые болевыми ощущениями в поражённой области, гнойными выделениями из носа, а также наличием гнойного налёта на миндалинах.
- Эндокардит (воспалительный процесс, местом локализации которого является сердечная оболочка).
- Абсцесс головного мозга, поражения спинного и головного мозга.
- Поражения органов дыхания, в частности, лёгких и плевры, что выражается в посинении губ, нехватке воздуха, появлении кашля с выделением гнойной мокроты.
- Поражения пищеварительной системы, сопровождаемые вздутием живота, тошнотой, рвотой, диареей и возникновением локального болевого синдрома.
- Поражение суставов и костной ткани, которое проявляется в покраснении кожных покровов в области локализации воспалительного процесса, появлении болей и скованности движений.
Помимо этого, каждая из указанных патологий сопровождается сонливостью, потерей аппетита, снижением работоспособности и повышением температуры тела. Такие симптомы появляются вследствие общей интоксикации организма.
Диагностика гемолитического стафилококка диагностика включает в себя комплексное бактериологическое исследование выделений, которые были получены из зева пациента. Основной целью проведения диагностических мероприятий является определение вида микроорганизма, который стал возбудителем инфекции. Ведь именно от этого зависит правильный выбор способа лечения, а также избавления от симптомов.
Обнаружить гемолитический стафилококк можно в посеве, который берётся с поражённого участка.
Лечение
Гемолитический стафилококк тяжело поддаётся лечению. Объясняется это некоторыми особенностями бактерии, обладающей повышенной жизнеспособностью. Бактерия может пережить многократную заморозку и оттаивание, а также пребывание под прямыми лучами солнца. Микроорганизмы неплохо себя чувствуют даже при высушивании в медицинских печах и сохраняют свою жизнедеятельность ещё в течение пяти месяцев после этого. Гибель стафилококка происходит при воздействии на него раствора фенола (5%), а также при кипячении. Микроорганизмы полностью исчезают после прижигания бриллиантовой зеленью.
Медикаментозное лечение
Всё более популярным методом лечения гемолитического стафилококка становится применение иммуномодуляторов, так как они воздействуют непосредственно на причину патологии, то есть понижение иммунитета. Такой вид лечения совершенно безопасен и не требует применения вредных для здоровья компонентов.
Следует учитывать, что к ослаблению иммунной защиты организма также может привести дефицит витаминов и минералов. Поэтому при лечении стафилококковой инфекции врачом назначается комплекс витаминов и минералов, которые не только способствуют быстрому выздоровлению, но и являются отличной профилактикой повторного инфицирования.
В тяжёлых случаях применяется антибактериальное лечение, физиотерапия, методы дезинтоксикации.
Для лечения патологий, вызванных стафилококком, используются определённые антибиотики, а также специальное средство, в состав которого входит бактериофаг.
Избавление от инфекции при помощи бактериофага
Бактериофагические средства показали высокую эффективность в борьбе с гемолитическим стафилококком. Для лечения используется бактерия, которая питается этими вредоносными микроорганизмами. Назначение препарата происходит только после точного установления штамма стафилококка, вызвавшего заболевание. Затем в организм мужчины вводится бактериофаг. Метод ввода препарата определяется местом локализации микроорганизмов.
Такое лечение показало положительные результаты при следующих недугах:
- патологии мочеполовой системы;
- гнойные абсцессы;
- гаймориты, гнойные поражения глотки и отиты;
- стафилококковое поражение кишечника;
- фолликулиты;
- фурункулёз мягких тканей.
Лечение стафилококка в мочеполовой сфере проводится с применением жидкого раствора бактериофага в чистом виде. Препарат вводится через специальный катетер. На третьи сутки терапии наступает гибель патогенных микроорганизмов. У мужчин инфекция наружных половых органов лечится примочками. При нагноениях на поражённом участке используется бриллиантовая зелень.
При инфекционном поражении желудочно-кишечного тракта и дисбактериозе кишечника бактериофагический препарат используется в форме таблеток, имеющих растворимую оболочку. Последняя, попадая в кишечник, растворяется и бактерия оседает на слизистой ткани. Продолжительность курса терапии определяется степенью поражения ЖКТ, но не может длиться более двух недель. При обнаружении вредоносных микроорганизмов в толстом кишечнике назначаются клизмы с раствором бактериофага.
Гнойная ангина лечится бактериями в чистом виде. Лекарственным средством орошают полость рта и глотки 2 раза/день. В течение часа после проведения процедуры не следует пить воду и принимать пищу.
Для лечения отитов применяется раствор бактериофага. Лекарственное средство при помощи пипетки закапывается в ушную раковину больного. Процедура проводится ежедневно, курс лечения составляет пять дней.
Обработка абсцесса проводится только специалистом в стационарных условиях. Для начала с поражённого участка снимается гнойная плёнка и всё тщательно просушивается. Ранку, находящуюся далеко в гортани, очищают при помощи катетера. Если нет возможности добраться до области поражения, то препарат вводится внутривенно. Курс лечения составляет от трёх до пяти дней.
Лечение фурункулёза и фолликулярного нагноения проходит особенно тяжело. Специалист назначает пероральный приём препарата в комплексе с инъекциями бактериофага.
Лечение стафилококка народными средствами
Терапия заболевания народными препаратами заключается в приёме различных настоев и отваром из лекарственных растений, а также принятии специальных лечебных ванн.
На начальной стадии стафилококка гемолитического можно использовать примочки или компрессы из тёплой воды (1 ст.) и яблочного уксуса (2 ст. л.). Уксус (не менее 100 мл) также можно применять для принятия лечебных ванн. Процедура проводится 3 раза/день. В дальнейшем по мере выздоровления количество процедур можно сократить.
Отлично справляется с бактериями стафилококка чёрная смородина, в которой содержится большое количество витамина C, способствующего укреплению иммунной системы организма. Существует мнение, что если на протяжении трёх-четырёх дней съедать по стакану этих ягод, то проблема стафилококка быстро разрешится.
Алоэ является мощным природным антибиотиком. Поэтому для борьбы с бактериями стафилококка рекомендуется принимать сок этого растения по 1 ч. л. каждый раз перед едой.
Эхинацея — сильный иммуностимулятор. Настойка, приготовленная на её основе, повысит сопротивляемость организма к различным вредоносным микроорганизмам (в том числе и бактериям стафилококка), а также усилит иммунитет.
Прополис — универсальное средство, которое является одновременно и антисептиком и природным антибиотиком и иммуностимулятором. А если учесть, что у стафилококка к прополису нет привыкания, как например, к медикаментозным антибиотикам, то для лечения инфекции этот природный продукт просто идеален.
Однако, какой бы способ лечения вы ни выбрали, перед его применением необходимо проконсультироваться со специалистом.
Лечение стафилококка гемолитического хлорофиллиптом
Если человек регулярно чувствует боль в горле после каждого съеденного мороженого или постоянно страдает ангиной, стоит задуматься о наличии стафилококка в гортани. Хлорофиллипт является одним из наиболее эффективных средств борьбы с бактериями. Этот препарат успешно применяется для лечения таких заболеваний, как тонзиллит, ангина и прочие поражения органов дыхательной системы.
Средство выпускается в виде спиртового раствора (для полоскания горла), масляного раствора (для смазывания миндалин), а также в виде спрея. Курс терапии хлорофиллиптом длится, как правило, не более четырёх дней. В целях ускорения процесса выздоровления можно принимать внутрь раствор этого препарата.
Если вы заметили, что гнойные заболевания стали вашими постоянными спутниками жизни — срочно обратитесь в клинику на предмет выявления стафилококка. Своевременная диагностика является гарантией успешного лечения.
urolog.guru
в уретре, в мазке, симптомы, лечение
Стафилококк у мужчин находится в мочеполовой системе. Эти микробы в ограниченном количестве приносят пользу, уничтожая омертвевшие клетки. Но некоторые их виды являются источником болезней. Они тяжело поддаются лечению.

Симптомы
При заражении микробами у пациента появляются такие признаки:
- Проблемы с оттоком мочи, боли в половом органе.
- Покраснение гениталий, их отёчность.
- Гнойные выделения из уретры.
- Когда есть такие симптомы необходима помощь специалиста.
Причины заражения
Мазок мужчины может содержать кокки. Появляются они по разным основаниям:
- Длительный приём антибиотиков.
- Заражение во время полового акта от партнёра, без использования презерватива.
- Понижение защитных сил организма после перенесённых инфекций.
- Другие заболевания мочеполовой системы.
- Нарушение целостности кожных в области паха, при травмах;
- Во время оперативного вмешательства.
Виды
Стафилококк имеет огромное количество штаммов. Наиболее серьёзные для мужчин:
Золотистый — один из самых опасных и трудно поддающихся лечению. Становится причиной 70 заболеваний. Бактерия очень жизнестойкая, не погибает от прямых солнечных лучей при обработке химическими препаратами.
Может развиваться в любом органе и вызывать воспаление:
- На коже появляются гнойные образования, фурункулёз.
- Возникают очаговые высыпания на слизистой половых органов, носа;
- При несвоевременном лечении вызывает отравление, токсический шок;
- Гнойная инфекция попадает в печень, почки, головной мозг;
- Может вызвать пищевое отравление.
Эпидермальный – менее опасен. Обитает на коже и слизистых поверхностях. При хорошей иммунной системе не приводит к заболеваниям. Опасен только при попадании в кровь. Это может произойти во время операций. В случае инфекции, которая с кровотоком попадает в сердце и вызывает внутреннее повреждение.
Сапрофитный – обитает на слизистой половых органов. Может вызвать боль в уретре и образование язв в мочевом пузыре. Приводит к частым циститам, в редких случаях может поражать внутренние органы.
Гемолитический – вызывает гнойные воспаления и инфекции на коже и на слизистых. Проявляет себя когда организм ослаблен. Вызывает ангину, скарлатину, воспаление легких, рожистые покраснения кожи.
Методы диагностики
Если на теле или слизистых мужчины есть очаги гнойной инфекции, берутся образцы для выращивания в бактериологической лаборатории. При поражениях внутренних органов сдаётся анализ крови из вены.
Кроме этих исследований делается тест на то, как бактерия реагирует на антибиотик Метицилин, используемый для лечения стафилококка.
Но есть такие штаммы, которые не реагируют на него, поэтому лабораторно подбираются другие группы для обеззараживания данного вида. Возможна комплексная терапия.
Лечение
Для устранения инфекции назначаются антибиотики. Основная группа — это те, что содержат Метицилин. Но есть много разновидностей бактерий, для которых необходимо подбирать другие группы препаратов.
- При наличии на коже больших гнойных очагов их надо вскрывать, чтобы уменьшить интоксикацию.
- Если инфекция расположена на внутренних органах, то ставится дренаж для оттока гноя.
- В случае если этих методов недостаточно, то хирургическим путем удаляются поражённые участки.
- Лечение инфекций длительное, надо начать вовремя.
Стафилококк, у мужчин с сильным иммунитетом, может самостоятельно справиться с инфекцией, при поддерживающей терапии.
Закаливайте свой организм, употребляйте больше фруктов и овощей, богатых витаминами, ведите здоровый образ жизни, соблюдайте правила гигиены. Это поможет избежать стафилококковой инфекции.
Заходите на наш сайт. Вы узнаете много новой и полезной для себя информации. Будьте здоровы!
flintman.ru
Стафилококк в уретре у мужчин: симптомы, чем лечить
Стафилококк в уретре у мужчин в небольшом количестве присутствует с самого рождения. При отсутствии благоприятных факторов бактерии не размножаются, их присутствие никак не отражается на состоянии здоровья. Но любой сбой может спровоцировать активный рост микробов, что станет причиной болезней мочеполовой сферы, включая достаточно тяжелые.

СодержаниеПоказать
Заражение стафилококком и стафилококковая инфекция — в чем разница?
загрузка…
Стафилококки – обширная группа шарообразных бактерий, которые относятся к условно-патогенным микроорганизмам, при нормальной работе иммунной системы абсолютно безопасны для человека.
Согласно последним исследованиям ВОЗ, только у 20% людей эти микробы присутствуют только на коже, в силу некоторых индивидуальных особенностей, у остального населения разное количество бактерий присутствует в кишечнике, на слизистых оболочках.

Стафилококковая инфекция возникает на фоне ослабленного иммунитета – бактерии начинают активно размножаться, развиваются различные патологии, которые сопровождаются повышением температуры, гнойными выделениями, сильными воспалительными процессами.
Заниматься самолечением стафилококковых инфекций опасно – бактерии имеют повышенную устойчивость к антибиотикам, без надлежащей терапии быстро размножаются, возникают тяжелые, а в некоторых случаях смертельные осложнения.
Виды бактерии
В природе существует около 30 штаммов стафилококка, но только некоторые из них опасны для человека. Бактерии селятся на коже, слизистых оболочках, с кровью могут проникнуть во все внутренние органы. Вредят здоровью не только микробы, но и токсические продукты жизнедеятельности, которые вызывают сильную интоксикацию.
| Штамм стафилококка | Описание | Какие болезни вызывает |
| Золотистый стафилококк (ауреус) | Опасный вид патогенных микробов, обитает во внешней среде, поражает все внутренние органы, плохо поддается антибактериальной терапии, процесс выздоровления может затянуться на несколько лет. | бактериальная пневмония, воспалительные процессы в головном мозге, печени, почках, заражение крови, токсический шок, остеомиелит, дерматологические гнойные заболевания, сильное пищевое отравление. |
| Эпидермальный стафилококк | Обитает на коже и слизистых, долго время может быть пассивным, но при сбоях в работе иммунной системы проникает в кровь. | воспаление эндокарда, летальный исход. |
| Сапрофитный стафилококк | Обитает микроб в области гениталий, чаще у женщин, мужчины заражаются при половых контактах, проникает в уретру. Хорошо поддается лечению. | цистит, уретрит, простатит, абсцесс половых органов, аденома простаты, бесплодие. |
| Гемолитический | Обнаружить микроб можно на кожных покровах и слизистых | тонзиллит, гайморит, скарлатина, бронхит, воспаление легких, кожные заболевания.
|
Уже через несколько часов после рождения у мальчиков можно обнаружить эпидермальный и сапрофитный стафилококк, бактерии заселяют первые 5 см уретры.
Пути заражения
Стафилококк проникает в организм различными путями, часто происходит самозаражение – бактерии, которые обитают на коже, через царапины проникают в кровь, разносятся по всему организму.

Как можно заразиться стафилококком:
- Контактный путь – микробы проникают в организм при незащищенном половом контакте, во время поцелуя. Много бактерий находится в слизи больного человека, выделяются во внешнюю среду при кашле, чихании.
- Бытовой путь – заразиться можно при пользовании общими предметами обихода, постельным бельем, бактерии присутствуют в пыле.
- Алиментарный путь – употребление зараженных бактериями продуктов, воды, чаще всего бактериальную инфекционную патологию провоцируют полуфабрикаты, блюда с майонезом и кремом.
- В медицинских учреждениях при использовании плохо продезинфицированных инструментов. Часто золотистый стафилококк диагностируют у людей, которые находятся в стационаре – любое серьезное заболевание подрывает иммунитет, что позволяет бактериям активно размножаться.
Спровоцировать развитие стафилококковой инфекции может длительный прием антибактериальных препаратов, хронические патологии мочеполовой системы, вредные привычки, эндокринные заболевания.
Стафилококки хорошо выживают вне человеческого организма, микробы могут жить без воздуха, не боятся высоких и низких температур, большинство антисептиков для них безвредны.
Симптомы патологического урогенитального процесса у мужчин
Когда в уретре стафилококки начинают активно размножаться, у мужчин возникают заболевания мочеполовой системы – патологии имеют ярко выраженные симптомы, игнорировать которые не получится, протекают в острой или хронической форме.

загрузка…
Признаки поражения уретры стафилококками:
- позывы к опорожнению мочевого пузыря возникают чаще, при этом наблюдаются проблемы с мочеиспусканием, боль, зуд, жжение;
- гениталии отекают, наблюдается их сильное покраснение, часто появляются гнойники в паховой области;
- меняется запах мочи, урина становится мутной, в ней могут присутствовать примеси крови;
- возникает сильный дискомфорт в нижней части живота, пояснице, лобковой области;
- выделения из уретры становятся обильными, в них присутствуют вкрапления гноя;
- припухлость одного или обоих яичек, при пальпации возникает болевой синдром;
- наблюдается локальное или общее повышение температуры.
Стафилококковые инфекции у мужчин диагностируют реже, нежели у женщин, но при этом у представителей сильного пола патологии протекают в более тяжелой форме, часто сопровождаются осложнениями.
Способы обнаружить возбудителя в уретре
Что говорят врачи о паразитах
Доктор медицинских наук, профессор Гандельман Г. Ш.:
Занимаюсь обнаружением и лечением паразитов уже много лет. С уверенностью могу сказать, что паразитами заражены практически все. Просто большинство из них крайне трудно обнаружимы. Они могут быть где угодно — в крови, кишечнике, легких, сердце, мозге. Паразиты в буквальном смысле пожирают вас изнутри, заодно отравляя организм. В итоге, появляются многочисленные проблемы со здоровьем, сокращающие жизнь на 15-25 лет.
Основная ошибка — затягивание! Чем раньше начать выводить паразитов, тем лучше. Если же говорить о лекарствах, то тут всё проблематично. На сегодняшний день существует только один действительно эффективный антипаразитный комплекс, это Toximin. Он уничтожает и выметает из организма всех известных паразитов — от головного мозга и сердца до печени и кишечника. На такое не способен больше ни один из существующих сегодня препаратов.
В рамках Федеральной программы, при подаче заявки до 12 октября. (включительно) каждый житель РФ и СНГ может получить одну упаковку Toximin БЕСПЛАТНО!
Чтобы обнаружить стафилококк в уретре, потребуется минимальное количество анализов – диагностика поможет определить штамм возбудителя, проверить его чувствительность к антибактериальным препаратам, направление можно получить у уролога, андролога.
Основные методы диагностики:
- Клинический анализ крови – проводят для выявления признаков воспалительного процесса и степени заражения бактериями.
- Общий анализ мочи – в норме количество лейкоцитов должно быть не более 2000 КОЕ/мл, эритроцитов – 1000 КОЕ/мл. Белок должен отсутствовать, о наличии воспаления свидетельствуют показатели более 30 мг/л.
- Трехстаканная проба – утреннюю урину собирают в 3 стерильные емкости, в I, III – примерно по 20% от общего количества, основную часть – во II контейнер. Если уровень лейкоцитов превышает норму только в I емкости – это показатель воспалительного процесса в уретре, если в I, III – инфекция поразила еще и простату.
- Бакпосев – один из наиболее информативных методов исследования, позволяет определить вид патогенного микроорганизма, его концентрацию, чувствительность к активным веществам антибиотиков.
- Антибиотикограмма – проводят с целью составления правильной схемы лечения.
- ПЦР – при помощи этого анализа можно обнаружить антитела к стафилококкам.
Пограничный показатель нормы стафилококка в мазке – 10 в 4 степени КОЕ/мл.
Чем лечить заболевания?
загрузка…
Для лечения стафилококковых инфекций применяют антибактериальные препараты на основе метициллина, но существуют некоторые штаммы, которые не реагируют на подобные лекарства – подобрать эффективное средство поможет предварительная диагностика.
Как лечить стафилококк в уретре:
- антибиотики из группы пенициллинов, тетрациклинов, макролидов, цефалоспоринов – Амоксициллин, Цефазолин, Цефотаксим, продолжительность терапии – 10 дней, препараты используют в виде таблеток, или в виде раствора, который вводят непосредственно в уретру;
- растворы с противомикробным действием – Фурацилин, препараты на основе колларгола, нитрата серебра;
- раствор стафилококкового бактериофага – содержат вещества, которые уничтожают только стафилококки, при этом не затрагивают полезные бактерии;
- антистафилококковая плазма – содержит антитела к стафилококку, оказывает бактерицидное действие, вводят внутривенно;
- иммуномодуляторы – антистафилококковый иммуноглобулин человека, вводят внутримышечно или внутривенно, на курс потребуется 5–7 инъекций;
- пробиотики – Линекс, Бифиформ, восстанавливают баланс микрофлоры после антибактериальной терапии.
При наличии обширных гнойных очагов поражения на коже перед началом лечения их вскрывают, при запущенных формах пораженные ткани удаляют. Если стафилококк поразил внутренние органы, устанавливают дренажную систему для усиленного отведения гнойного содержимого.

Во время лечения стафилококковых урогенитальных инфекций особое внимание следует уделить питанию. В рационе не должно быть продуктов, которые раздражают воспаленные органы – острая, пряная, жирная, копченая пища.
Помогут облегчить течение болезни продукты с мочегонным действием – кабачки, огурцы, арбузы, противомикробным действием обладает брусника, клюква, продукты пчеловодства, спаржа, сельдерей. Кисломолочная продукция с умеренным содержанием жира способствует восстановлению кишечной микрофлоры.
Профилактика
Каждому мужчине под силу защитить свой организм от стафилококковых инфекций, для этого необходимо соблюдать простые правила профилактики.
Как предотвратить заражение стафилококком:
- пользоваться презервативами, реже менять половых партнеров;
- отказаться от пагубных привычек;
- ежедневно включать в рацион свежие сезонные овощи и фрукты;
- не забывать о регулярных физических нагрузках;
- каждое утро принимать контрастный душ;
- не пить сырую воду;
- соблюдать правила личной гигиены;
- избегать контактов с людьми, у которых присутствуют явные признаки заболевания;
- прививка от стафилококка позволяет сформировать устойчивый иммунитет к патогенным микроорганизмам.
При сильном иммунитете, отсутствии хронических заболеваний, организм мужчины может самостоятельно справиться с любой стафилококковой инфекцией.
Видео посвящено лечению мужского уретрита:
Стафилококк в уретре у мужчины встречается нечасто, но если бактерия проникнет в мочеполовую систему, начнут развиваться воспалительные процессы, что чревато импотенцией и бесплодием. При появлении признаков заражения необходимо посетить уролога, только после тщательной диагностики можно составить правильную схему лечения.
загрузка…
otparazitoff.ru
Гемолитический стафилококк у мужчин и способы борьбы с ним
Гемолитический стафилококк у мужчин вызывает множество заболеваний. Патологии, вызванные стафилококком, протекают у человека в скрытой форме. Выявить заболевание на ранних стадиях можно при прохождении медицинского обследования. Лечение стафилококка необходимо проводить на раннем развитии, чтобы избежать появление осложнений.

Как выглядит бактерия
Гемолитический стафилококк представляет собой микроорганизм шаровидной формы. Размер взрослой бактерии достигает 1,2 мкм. Микроорганизмы селятся небольшими колониями. Под микроскопом колония выглядит как гроздь винограда. Гемолитический стафилококк относится к классу бактерий, отряду бацилл. Бактерия является патогенной микрофлорой мужского организма.
На быстрый рост колонии влияет иммунная система. При снижении местного иммунитета стафилококк начинает активно размножаться и питаться тканями на поврежденном участке. Гемолитический стафилококк вызывает некроз тканей и заражение кровеносной системы. Бактерия обладает высокой устойчивостью ко многим антибиотикам, хорошо переносит перепады температур. При повышении температуры окружающей среды до 70 градусов стафилококк способен жить до 12 часов. Благодаря устойчивости бактерии к антибиотической терапии заболевание является трудноизлечимым.
Патологии, указывающие на наличие бактерии
Гемолитический стафилококк выявить самостоятельно невозможно. Распознать бактерию можно только при наличии следующих заболеваний у мужчин:
- Появление фурункулов на разных участках кожи;
- Наличие гнойного абсцесса в гортани;
- Экземы различной этиологии;
- Кожный нейродермит;
- Блефарическое поражение глаза;
- Развитие пневмонии при поражении легких;
- Воспалительные процессы в волосяных фолликулах;
- Некроз почек и желчного пузыря;
- Гнойное воспаление ткани головного мозга;
- Септическое заражение крови.
Бактерия влияет на появление осложнений. При поражении стафилококком ушей у мужчины возникает гнойный отит. Если бактерия попала на слизистую оболочку носа и глотки, могут возникнуть гнойные ангины и гаймориты. Опасность бактерии заключается в развитии гнойной инфекции и устойчивость к антибиотикам. Самой тяжелой патологией, вызванной гемолитическим стафилококком, является сепсис. Если своевременно не обратиться за амбулаторным лечением, мужчина может погибнуть.
Причины развития бактериальной инфекции
На развитие колоний бактерий влияет снижение иммунной системы мужчины. Стафилококк может вызвать вторичное инфицирование ткани. Так, при появлении ран на теле бактерия провоцирует образование нагноения в ткани. В пораженном органе или ткани бактерия поселяется на место погибшей микрофлоры. Так как микроорганизм способен вызывать некроз, то клетки на пораженном участке отмирают и появляется гнойное воспаление. Стафилококк вызывает сильное отравление поврежденной ткани благодаря экзотоксину, который он вырабатывает.
У мужчин на появление инфекции влияют следующие причины:
- Несоблюдение правил личной гигиены;
- Наличие на теле различных травм;
- Ослабление иммунной системы;
- Инфекционные заболевания различной этиологии.
Гемолитический стафилококк вызывает инфекционное поражение мочеполовой системы у мужчин. В мочевыводящий канал бактерия попадает из внешней среды. Стафилококк вызывает циститы, гнойные уретриты. У некоторых мужчин стафилококк вызывает гнойное поражение наружных половых органов. Причиной инфекции мочеполовой системы чаще всего является тесное нательное белье.
Методы борьбы с бактерией
Гемолитический стафилококк трудно поддается лечению. Связано это с некоторыми особенностями микроорганизма.
Бактерия обладает высокой жизнестойкостью. Микроорганизм способен пережить многократное замораживание и оттаивание. Солнечное освещение не оказывает пагубного воздействия на стафилококк. Бактерии хорошо переносят высушивание в медицинских печах. После высушивания бактерия сохраняет жизнедеятельность в течение пяти месяцев. Гибель микроорганизмов возникает при кипячении и воздействии на них 5% раствора фенола. Стафилококк полностью пропадает при местном применении бриллиантовой зелени.
Для лечения инфекций, вызванных гемолитическим стафилококком, применяют узкий ряд антибиотических лекарственных веществ и специальный препарат, содержащий бактериофаг. Быстрых положительных результатов в терапии помогает достичь прием иммунных лекарственных веществ.
Уничтожение инфекции бактериофагом
Высокой активностью против стафилококка имеют бактериофагические препараты. Для терапии используют бактерию, питающуюся стафилококком. Для назначения бактериофага необходимо выяснить штамм стафилококка, вызвавшего инфекцию. После точного определения заболевания мужчине вводят препарат. Методы ввода бактериофага разнообразны и зависят от места локализации колоний. Положительные результаты бактериофагическое лечение показало при следующих патологиях:
- Отиты, гнойные поражения глотки и гаймориты;
- Гнойные абсцессы;
- Стафилококковое поражение кишечника;
- Мочеполовые заболевания;
- Фурункулез мягких тканей;
- Фолликулиты.
Для терапии отитов используется разведенный жидкий бактериофаг. Препарат употребляется капельно в ушную раковину. Процедура проводится в пятидневный период с ежедневным закапыванием бактериофага.
При гнойной ангине применяют жизнеспособные бактерии в чистом виде. Препаратом орошают полость глотки и рта. Терапия длится 10 дней. Орошение проводится двукратно в течение дня. После приема препарата не следует принимать пищу и воду в течение часа.
При дисбактериозе кишечника и инфекциях желудочно-кишечного тракта бактериофаг применяется в виде таблеток. Таблетированная форма имеет кишечнорастворимую оболочку. Оболочка при попадании в кишечник растворяется, и бактерия попадает на слизистую ткань. Длительность лечения зависит от степени поражения желудочно-кишечного тракта, но не превышает двухнедельного срока. При проникновении стафилококка в толстый кишечник мужчине назначается применение клизм с раствором лекарственного вещества.
Для лечения стафилококка в мочеполовой системе применяют жидкий раствор бактерий в чистом виде. Лекарственное средство вводят через специальный катетер. Лечение необходимо провести в стационаре. Гибель микроорганизма наступает на третьи сутки лечения бактериофагом. При инфекции наружных половых органов у мужчин используют примочки. Если на пораженном участке имеется нагноение, то совместно с бактериофагом наносится бриллиантовая зелень.
Фолликулярное нагноение и фурункулез требует сложного лечения. Мужчине назначается прием препарата внутрь и инъекции бактериофагом. Пораженный участок обкалывают препаратом местно. Для быстрого лечения необходимо провести пять процедур. Местное обкалывание проводят через день в больнице. Прием бактериофага помогает убить стафилококк изнутри.
Абсцесс может обрабатывать только специалист. Для начала процедуры с области, пораженной абсцессом, снимают гнойную пленку и убирают всю жидкость. Если нагноение находится глубоко в гортани, чистку раны проводят при помощи катетера. После тщательной просушки раны наносится раствор бактериофага. Если до пораженного участка невозможно добраться, то проводят внутривенное вливание препарата. Лекарство вводится через систему в течение 3–5 дней.

Медикаментозная терапия
Стафилококк тяжело поддается лечению антибиотическими лекарственными средствами. Если при бактериальном посеве микроорганизм показывает активность по отношению к широкому спектру антибиотиков, то при применении стафилококк может и не погибнуть. В современной фарминдустрии разработали три антибиотика, которые эффективны против стафилококковой инфекции у мужчин:
- Ванкомицин в виде раствора для внутривенного введения;
- Даптомицин;
- Линезолид.
Ванкомицин обладает широким спектром действия. Эффективность препарата связана с механизмом его действия. Лекарственное вещество влияет на мембрану бактерии, способен изменить структуру РНК, делает стафилококк неактивным. Для лечения применяют порошок для приготовления раствора. Препарат следует готовить непосредственно перед процедурой. Применение ванкомицина не всегда целесообразно. У мужчины могут иметься в анамнезе противопоказания к применению. Так, препарат не назначается при неврите слухового прохода, наличии почечной недостаточности. Перед использованием ванкомицина у мужчины проводят тест на восприимчивость. Антибиотик является высокотоксичным и плохо переносится. Лечение стафилококка ванкомицином занимает пять дней.
Даптомицин разработан относительно недавно. Препарат относится к циклическим липопептидам. Лекарственное вещество применяется в виде систем. Даптомицин вызывает деполяризационный процесс в клеточной мембране стафилококка. При быстром ингибировании синтеза пептида микроорганизм погибает. Лечение антибиотиком проводят в стационаре, так как препарат вызывает различные побочные эффекты. Препарат не используют у мужчин, имеющих токсичные поражения почек. Терапия даптомицином проводится в течение пяти дней и вызывает полную гибель бактерии. Так как препарат обладает узким спектром действия, имеет высокую стоимость. Цена за один флакон даптомицина достегает 7100 р.
Линезолид назначается мужчине, если применение ванкомицина оказалось неэффективным. Лекарство выпускается в виде растворов для внутривенного введения и пилюль. Для терапии гемолитического стафилококка у мужчин применяется внутривенный раствор. Терапию проводят в пятидневный период. Инфузия ставится разово в сутки. Капельница проводится медленно и должна проходить не менее 30 минут. Лизенолид используют для лечения инфекций, вызванных грамположительными бактериями. Препарат имеет высокую стоимость. Один флакон медикамента может стоить 4 тыс. р. Лекарственное вещество взаимодействует с тиролом. Запрещается принимать пивные напитки и копченые продукты в течение всего лечения.
Самостоятельное применение антибиотиков может привести к осложнениям.
Мужчине необходимо знать наличие хронических заболеваний и патологических процессов в организме. Все препараты являются токсичными для почек. Если проводить терапию без врачебного контроля, у мужчины может возникнуть некроз почечной ткани.
Профилактика заболевания
Заражение гемолитическим стафилококком можно избежать. Мужчине необходимо строго соблюдать правила личной гигиены. При обнаружении ран и травм кожи необходимо незамедлительно использовать антибактериальный раствор или зеленку. При посещении общественных мест следует использовать влажные антибактериальные салфетки. Если в доме проживает мужчина, имеющий стафилококковую инфекцию, всем членам семьи следует пользоваться индивидуальными полотенцами и посудой. Нательное белье мужчине необходимо выбирать не тесное, произведенное из натуральных материалов. Для мытья тела можно применять антибактериальный гель или мыло. После посещения улицы следует мыть руки, и обязательно проверять наличие ран и ссадин на теле.
Если мужчина обратил внимание на частые гнойные заболевания, то ему необходимо обратиться к специалисту за консультацией. Бактериальный посев поможет выявить причину заболевания.
doktorsos.com
лечение инфекции в мочеполовой системе
Стафилококк у мужчин – инфекционное заболевание, которое возникает из-за действия жизнестойких патогенных микроорганизмов. Стафилококки могут локализоваться в слоях кожи на любом участке тела, в половых путях, а также носовых ходах. Симптоматика инфекционного поражения зависит от степени распространенности патологического процесса, а также от разновидности патогена.
Клиническая картина

Наибольшую опасность для мужчины представляют такие виды стафилококка:
- золотистый. Бактерия этого вида устойчива к внешним условиям и способна вызывать более 70 заболеваний. Золотистый стафилококк становится причиной гнойных образований на коже. Опасность заключается в вероятности проникновения инфекции в головной мозг, печень и другие органы;
- эпидермальный. Этот болезнетворный микроорганизм локализуется на кожных покровах и слизистых оболочках. Наибольшую опасность представляет при проникновении непосредственно в кровь, что может произойти при проведении хирургических вмешательств;
- гемолитический. Этот вид бактерии активизируется на фоне ослабленного иммунитета. Гемолитический стафилококк становится причиной гнойных воспалительных процессов на коже и слизистых. Может вызывать такие заболевания, как воспаление легких, ангина;
- сапрофитный. Стафилококк поражает преимущественно слизистые оболочки половых органов. Бактерия вызывает уретрит, рецидивирующий цистит.
Проявления стафилококковой инфекции у мужчин чаще всего выражаются в поражении мочевыводящей системы. Также вероятны кожные проявления и интоксикация организма.

Симптоматика заражения стафилококками выражается в следующем:
- затрудненное мочеиспускание;
- болевые ощущения в мочевом канале;
- неприятный запах, исходящий от мочи;
- помутнение урины;
- покраснение и отечность наружных половых органов;
- тянущие боли в паху;
- жжение в уретре;
- боли, возникающие при прикосновении к половому члену;
- дискомфорт и боли, возникающие при половом акте;
- слизистые выделения из половых путей со следами гноя, имеющие неприятный запах.
При благоприятных условиях для размножения стафилококки продвигаются по уретральному каналу и поражают все органы мочеполовой системы мужчины.

Причины
Патологию инфекционного характера вызывают такие причины:
- продолжительный прием антибактериальных препаратов;
- занесение патогенной бактерии в кровь при проведении хирургических вмешательств;
- половые акты без использования барьерных средств контрацепции с зараженным партнером;
- снижение защитных сил организма, что вызвано длительными заболеваниями;
- нарушение кожных покровов в области паха;
- заболевания мочеполовой системы хронического характера.
Мужчина может заразиться стафилококком следующими путями:
- контактным, то есть при незащищенном половом акте, при поцелуе;
- бытовым. Развитию инфекционного процесса может способствовать пользование общими с зараженным человеком предметами гигиены и обихода;
- алиментарным. В этом случае бактериальная инфекция развивается при употреблении продуктов и воды, в которых имеется стафилококк.

Использование нестерильных инструментов в медицинских учреждениях при проведении оперативных вмешательств также вызывает инфекционное заболевание.
Методы диагностики
Для выявления заболевания назначают проведение таких диагностических процедур, как:
- клинический анализ крови;
- общий анализ урины;
- мазок из уретры;
- бактериальный посев;
- анализ на чувствительность имеющегося штамма стафилококка к антибиотику Метициллин.
Если в результате проведенных исследований было выявлено, что в мазке, посеве или в сперме присутствует стафилококк, но титр низок, то усилия направляют на устранение инфекции. В таком случае бактерия не оказывает значительного влияния на самочувствие мужчины, его потенцию и репродуктивные способности.
В более запущенных случаях, при стафилококке на фоне воспалительных процессов, распространяющихся на мочеполовую область, назначается комплексное лечение.

Медикаментозное лечение
В ходе лечения стафилококковой инфекции у мужчин назначают следующие лекарственные средства:
- антибиотики. При симптомах стафилококкового поражения курс антибактериальной терапии продолжается в течение 10 дней. Больным назначают прием средств Амоксициллин, Левофлоксацин, Цефазолин. В случае осложненного течения заболевания показана комбинированная терапия антибиотиками. Специалист выбирает одну из схем лечения, например, комбинирует пероральный прием средства Ципрофлоксацин с его внутривенным введением либо назначает введение Цефазолина и Цефтриаксона внутривенно;
- раствор стафилококкового бактериофага. Средство используется как для местного применения, так и для перорального приема. Активное вещество раствора позволяет уничтожить стафилококки, не оказывая при этом влияния на полезные бактерии;
- растворы для местного применения, оказывающие противомикробное действие. Это препараты на основе нитрата серебра, Фурацилин.
Развивающийся в течение длительного времени стафилококковый уретрит может стать причиной простатита, импотенции, орхита, везикулита. Чтобы не допустить осложнений, следует обращаться к врачу при первых признаках инфекционного процесса.

В большинстве случаев заболевание излечивают при помощи консервативных методов, но иногда прибегают к хирургическому вмешательству. При стафилококке в простате показаниями к операции выступают такие осложнения, вызванные бактериями, как острая задержка мочи, абсцесс или аденома простаты.
Коррекция образа жизни
При стафилококковой инфекции в уретре мужчине также необходимо скорректировать общий режим, пересмотреть привычки, наладить питание.
Рекомендуется делать следующее:
- уделять особое внимание личной гигиене;
- убрать из рациона копчености, жирную и острую пищу, пряности;
- укреплять иммунитет;
- чаще бывать на свежем воздухе;
- кушать больше свежих фруктов и овощей.
В ходе лечения необходимо избегать переохлаждения организма.
Польза физиотерапевтических процедур
Цель проведения физиотерапевтических процедур при стафилококковой инфекции у мужчин – восстановить нормальное кровообращение в области малого таза, а также наладить процесс нарушенного мочеиспускания.
В данном случае эффективны лазеротерапия, ультразвуковая терапия, магнитотерапия, озонотерапия.
Профилактика
Чтобы предотвратить вероятность развития стафилококковой инфекции в простате у мужчин, следует помнить о ряде правил. Необходимо:
- пользоваться презервативами при половых контактах с непроверенными партнерами, которые могут являться носителями инфекции;
- отказаться от вредных привычек, которые снижают иммунитет и делают организм более уязвимым перед различными бактериями;
- вовремя делать прививку от стафилококка;
- отказаться от любых контактов с людьми, у которых явно выражена симптоматика стафилококковой инфекции;
- повышать иммунитет путем занятий спортом, закаливания, потребления достаточного количества витаминов;
- соблюдать правила гигиены;
- отказаться от употребления немытых овощей и сырой воды.
Стафилококковая инфекция у мужчин – патологическое состояние, которое при неблагоприятном течении может вызвать ряд осложнений. Чтобы этого не допустить, необходимо немедленно обратиться к врачу и начать курс лечения.
dermatologiya.su
Staphylococcus haemolyticus у мужчин: эффективные способы излечения
Стафилококки — эта большая группа бактерий, которые вызывают у человека различные инфекционные заболевания, грозящие трудноизлечимыми осложнениями. К этому отряду патогенных вирусов относится и Staphylococcus haemolyticus, или гемолитический стафилококк. Эти бактерии имеют размеры от 0,7 до 1,1 мкм. Относятся к так называемым грамположительным коккам. Форма микроба — сферическая. Они располагаются в организме мужчины в виде неравномерных скоплений, которые напоминают своей структуре виноградную гроздь.
Их вредоносное воздействие основано на выделении экзотоксина, который обладает некротическим и гемолитическим действием на организм. Стафилококк гемолитический (Staphylococcus haemolyticus) у человека может вызвать следующие заболевания:
- различные гнойные воспалительные процессы на разных органах;
- сепсис и поражение кожного покрова, эндокардит;
- поражения уретры и цистит.
Симптомы поражения мужчин стафилококковой инфекцией
Основные признаки заболевания относятся следующие факторы:
- появляются фурункулы;
- возможны гнойные абсцессы;
- проявляется экзема в различных формах;
- разного рода дерматиты;
- блефариты и панариции;
- появляются карбункулы;
- проявляются симптомы пневмонии или пиодермии;
- остеомиелиты;
- образуются фолликулиты;
- возможно появление симптомов периоститов или холецистита;
- возникают сикозы;
- менингит;
- проявляются поражения аппендикса (аппендицит).
Стафилококки могут вызвать и вторичные поражения при таких заболеваниях, как грипп, оспа, послеоперационные осложнения в виде нагноений,инфицирование различных ран на теле человека. У детей Staphylococcus haemolyticus вызывает симптомы таких болезней, как:
- стафилококковая пневмония;
- сепсис.
Эти заболевания страшны для маленьких пациентов своими осложнениями и часто оканчиваются для них летальным исходом.
При комбинированном инфекционном поражении больного стафилококки вместе со стрептококками могут вызвать такие болезни:
- туберкулез;
- дифтерия;
- ангина;
- нагноения при инфицировании ран;
- актиномикоз;
- грипп и парагриппозные состояния;
- различные формы поражения дыхательных путей.
Стафилококки своим воздействием резко снижают способность иммунной системы мужчин адекватно отвечать на инфекционные поражения. Для развития этих бактерий повреждение кожного покрова мужчины — самая благоприятная среда. Этому способствует нарушение правил гигиены, трение кожи об одежду, занозы и небольшие ранки. Стрессовые ситуации, нерациональное питание, гиповитаминоз и общее снижение иммунитета позволяют стафилококкам беспрепятственно проникать в различные органы и ткани, инфицируя их. Это может привести к появлению симптомов остеомиелита. При проникновении в грудную клетку мужчины эти вирусы вызывают гнойный мастит. Они проникают со слизистой оболочки дыхательной системы в легкие, пазухи носа, ушные полости. При этом стафилококки разных видов действуют в «кооперации» друг с другом, что вызывает одновременное поражение организма человека различными болезнями.
Лечение инфекций, вызванных стафилококками
Трудность борьбы с этими видами бактерий обуславливают такие факторы, как:
- устойчивость этих вирусов к высушиванию;
- очень хорошо себя они чувствуют при замораживании;
- на эти бактерии не действует солнечный свет;
- они устойчивы к воздействию многих химических веществ.
При их высушивании бактерии сохраняют свою жизнедеятельность в течение ½ года, при воздействии на них пыли они живут до 3-х месяцев. Стафилококки не погибают ни при первом, ни при повторном их замораживании и оттаивании, а действие прямого солнечного излучения эти вирусы могут выдержать на протяжении нескольких часов.
Бактерии могут перенести нагревание до 68-72°С в течение 1,5 часов. При подъеме температуры еще на 10°С стафилококки могут поддержать свою жизнедеятельность от 12 минут до часа, а при кипячении микробы гибнут мгновенно.
Убить стафилококки можно за полчаса, применив 5% фенольный раствор. Этот результат можно получить и при использовании анилиновых красителей — бактерии чувствительны к ним. Особенно действует на эти патогенные вирусы бриллиантовый зеленый, который применяют для борьбы с гнойниками на кожном покрове человека, вызванными стафилококками.
Современная медицина использует для борьбы с этими вирусами следующие методы:
- курс лечения с помощью антибиотиков и противомикробных препаратов;
- различные виды хирургического вмешательства;
- с использованием разных пищевых добавок (кордицепс, хитозан), минеральных препаратов, витаминов для нормализации гормонального статуса и оптимизации процесса обмена веществ в организме пациента;
- иммунное модуляционное лечение.
Эффективные способы излечения (использование бактериофагов)
Самым эффективным методом на данном этапе развития медицины считается применение для излечения болезней, вызванных стафилококками, так называемых бактериофагов.
Это сообщество фагов, которые уничтожают бактерии этого вида, выделяющиеся при гнойных инфекционных поражениях организма человека.
Этот метод используется для борьбы с такими заболеваниями, как :
- поражение слизистых оболочек;
- синусит;
- ангины разного вида;
- отит;
- фарингит и ларингит;
- бронхит и трахеит;
- гнойные поражения кожи;
- плевриты;
- разные формы пневмонии;
- абсцесс;
- нагноение различных ран;
- подвергшиеся инфицированию ожоги;
- фурункулы и карбункулы;
- гидраденит;
- флегмона и панариции;
- мастит и бурсит;
- остеомиелит;
- парапроктит;
- цистит и холецистит;
- уретрит и пиелонефрит;
- эндометрит;
- гастроэнтероколит;
- омфалит;
- сепсис;
- поражения кишечника при дисбактериозе.
Применяемый для лечения больных препарат является фильтратом фаголизата, который проявляет особую активность против стафилококковых бактерий различного типа. Важным условием применения выбранного для лечения бактериофага является определение его воздействия на выделенный у больного штамм подлежащей уничтожению бактерии. После того как получен положительный ответ на проведенное исследование фага, его вводят пациенту. Обычно курс терапии этим методом продолжается 7-16 дней.
Методы ввода фага в организм больного зависят от характера инфекционного поражения пациента и бывают следующих типов:
- местное орошение, тампонирование или примочки;
- внутрикожные инъекции;
- введение через брюшную полость, плевру или между суставами;
- ввод посредством катетера через мочевой пузырь.
Если рецидивы болезни повторяются, то курсы лечения бактериофагами можно продолжить. При местном орошении (примочках и тампонировании) жидким фагом смазывают (смачивают) пораженный участок. Для большего эффекта при таких гнойных поражениях желательно провести одновременно и ввод фага через рот больного. Курс длится до 20 дней.
Как лечить стафилококки с помощью фагов?
Если воспалительные процессы и нагноения возникли в ухе, горле или носе и была выявлена причастность к ним стафилококков, то бактериофаг вводят в форме полосканий, промываний или закапывают в полости больного органа.
Если образовались фурункулы (карбункулы), то жидкий фаг вносится прямо в место поражения и вокруг него. Инъекции делают ежедневно, увеличивая дозу препарата через сутки. За весь курс лечения таким методом проводят до 5 инъекций. Длительность излечения составляет около недели.
При развитии абсцесса бактериофаг вносится в полость очага при помощи инъекции, после того, как методом пункции удален гной из тела пациента. По объему вводимый фаг должен быть меньше удаленного гнойника. Вскрывают абсцесс и вносят в это место тампон, смоченный в жидком фаге.
Если диагностирован хронический остеомиелит, то препарат заливают в рану после хирургического вмешательства. При использовании бактериофага против глубоких форм пиодермита производят внутрикожные вливания в одно место поражения. При многочисленных очагах поражения дозу повышают и распределяют по всем местам, где обнаружена стафилококковая инфекция. Больному ставят капиллярный дренаж и через него вводят фаги через день. Норма — не больше 4-х вливаний.
Если назначено лечение от цистита, то лекарство вводится через мочевой пузырь с помощью катетера. Гнойные бурситы, плевриты и артриты излечивают вводом бактериофага в очищенную от гноя полость очага поражения. Это делают через день, но не более 4 раз за весь курс терапии.
Если диагностировано поражение мочеполовой системы и развитие уретрита, то фаги применяют в виде таблеток. То же используют при развитии патологии (цистита, пиелонефрита и других).
Если поражен кишечник и проявился дисбактериоз, то фаги используют в жидком виде, принимая их натощак 3 раза в сутки за 2 часа до еды. Можно это делать и 1 раз в сутки при помощи клизм или в виде свечей. Курс лечения занимает 2 недели под строгим бактериологическим контролем со стороны лечащего врача. Если надо применить лекарство для лечения новорожденного, то его разводят в кипяченой воде. Если нет отрицательной реакции организма ребенка (отрыжка или высыпания на кожном покрове), то в дальнейшем можно давать уже неразведенный фаг, смешав его с грудным молоком.
Если у новорожденного энтероколит или сепсис, то ребенку (в том числе и недоношенному) вводят бактериофаг через катетер или газоотводную трубку 3 раза в сутки. Это можно сделать и через рот или с помощью клизмы. Если есть необходимость излечения ребенка от пиодермии, омфалита или инфицированной ранки, то жидкие фаги при помощи марлевой салфетки накладывают на пораженный участок кожи или ранку на пупке. Это делают дважды в день.
Профилактическое лечение
Для профилактики послеоперационных ран применяют бактериофаги в виде орошения.
Если нужно произвести профилактику внутриутробной инфекции стафилококками, то препарат применяют в виде клизм 2 раза в сутки. Курс терапии длится неделю. Эти же нормы используют при профилактике сепсиса и энтероколита у новорожденных или при опасности внутрибольничной эпидемии, вызванной стафилококками.
В форме аэрозоля фаги используют для орошения очага гнойного поражения кожного покрова, при ожогах, инфицировании ран, гнойных воспалениях, для лечения ангины.
Наиболее эффективно использование бактериофага при инфекции устойчивым к антибиотикам штаммом стафилококка.
Тогда рекомендуется провести комбинированное лечение с помощью антибактериальных препаратов, антибиотиков и фагов. Надо только учесть, что перед применением фага следует промыть место поражения 2%-ным раствором соды, если до этого больному давали для лечения антибиотики.
x
Противопоказаний и реакций на введение пациенту бактериофага не установлены. При инъекции возможно местное раздражение в виде красноты, но оно очень быстро проходит. Иногда случаются и воспаления, но они не опасны и спадают через 1-2 дня. Это является нормой.
Стафилококковые инфекции опасны по своим последствиям, поэтому надо сразу обратиться к врачу.
kakbik.ru
Антибактериальные препараты назначают после проведения специального теста на чувствительность выделенного микроорганизма к противомикробным средствам. Гемолитический стафилококк имеет повышенную устойчивость к некоторым антибиотикам. Чаще всего используют пенициллины «Амоксициллин», «Аугментин», цефалоспорины «Цефалотин», «Цефтриаксон», макролиды «Азитромицин», «Кларитромицин», а также «Ванкомицин», «Оксациллин». Лечение антибиотиками начинают, когда количество колониеобразующих единиц стафилококка превышает 10 в 4 степени. Антибиотикотерапия длится обычно 10-14 дней.